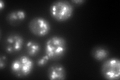

View description
Delta(24)-sterol C-methyltransferase, converts zymosterol to fecosterol in the ergosterol biosynthetic pathway by methylating position C-24; localized to both lipid particles and mitochondrial outer membrane
Localization:
Intensity:
Fold change:
Significance:
-
C’ GFP library in SD

punctate161.8 -
N' NOP1pr-GFP in SD

punctate237.65 -
N' TEF2pr-mCherry in SD

ER,punctate399.567 -
N' NATIVEpr-GFP in SD

ER,punctate192.832 -
N' TEF2pr-VC and Cyto-VN in SD

punctate71.8694 -
C’ GFP library in SD+DTT
punctate177.531.09No -
C’ GFP library in SD+H2O2

punctate168.431.04No -
C’ GFP library in Starvation Media

punctate246.11.52Yes -
C’ GFP library on the background of Pup2-DaMP

punctate -
C’ GFP library on the background of CCT mutant

punctate154.0430.952016No
